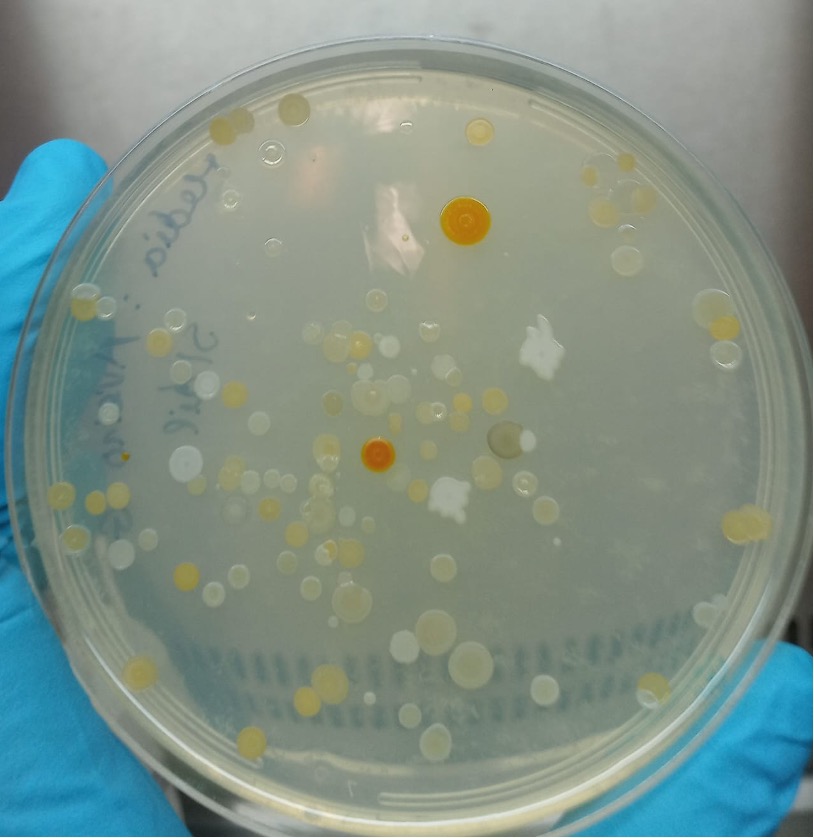

Team led by USJ Scholar discovers new species of bacteria in salterns from Portugal

Team led by USJ Scholar discovers new species of bacteria in salterns from Portugal
07
Aug
07/08/2025
The authors team is led by Prof. André Antunes, Acting Dean of the Institute of Science and Environment (ISE) of the University of Saint Joseph (USJ), Macao.
A recent publication reports on the isolation and characterisation of new species of bacteria from samples collected in the saltern of Rio Maior, Portugal. The authors team is led by Prof. André Antunes, Acting Dean of the Institute of Science and Environment (ISE) of the University of Saint Joseph (USJ), Macao. The team also includes other researchers from Macao (Macau University of Science and Technology; coordinated by Prof Marta Filipa Simões), Portugal (University of Minho; coordinated by Prof Lígia Rodrigues) and Spain (University of Sevilla; Prof Rafael de la Haba).
The article was published in the prestigious International Journal of Systematic and Evolutionary Microbiology, the journal of record for publication of novel microbial taxa and the official publication of the International Committee on Systematics of Prokaryotes and the Bacteriology and Applied Microbiology Division of the International Union of Microbiological Societies.
The publication resulted in the establishment of the new species Fodinibius alkaliphilus and also includes the reclassification of a previously known species into the same genus (as Fodinibius salipaludis). The new species grows best at salinities that are around 4 times higher than seawater and also preferred alkaline conditions, this combining the capability to grow under different environmental extremes.
This publication highlights the strengths of Macao in articulating with partners in Portuguese and Spanish-speaking countries, and its increased standing in the fields of Biodiversity and Biotechnology. The study of such extreme environments is relevant for future applications in a wide range of fields, including biomedical and pharmaceutical but also extends to the discovery of useful new materials and to providing useful insights for future efforts in space exploration. Further samples from these sites are currently being investigated and further publications describing other new species are expected within the next few months.
(Português)
Equipa liderada por Académico da USJ descobre novas espécies de bactérias em salinas de Portugal
Uma publicação recente relata o isolamento e caraterização de novas espécies de bactérias a partir de amostras recolhidas na salina de Rio Maior, Portugal. A equipa de autores é liderada pelo Prof. André Antunes, Director em exercício do Instituto de Ciência e Meio Ambiente (ISE) da Universidade de São José (USJ), Macau. A equipa inclui ainda outros investigadores de Macau (Universidade de Ciência e Tecnologia de Macau; coordenada pela Prof.ª Marta Filipa Simões), de Portugal (Universidade do Minho; coordenada pela Prof.ª Lígia Rodrigues) e de Espanha (Universidade de Sevilha; Prof. Rafael de la Haba).
O artigo foi publicado no prestigiado International Journal of Systematic and Evolutionary Microbiology, a revista de referência para a publicação de novos géneros microbianos e a publicação oficial do Comité Internacional de Sistemática de Procariotas e da Divisão de Bacteriologia e Microbiologia Aplicada da União Internacional das Sociedades de Microbiologia.
A publicação resultou no estabelecimento da nova espécie Fodinibius alkaliphilus e inclui também a reclassificação de uma espécie anteriormente conhecida no mesmo género (como Fodinibius salipaludis). A nova espécie cresce melhor em salinidades que são cerca de 4 vezes superiores à água do mar e também prefere condições alcalinas, combinando assim a capacidade de crescer em diferentes extremos ambientais.
Esta publicação destaca os pontos fortes de Macau na articulação com parceiros dos países de língua portuguesa e espanhola e a sua posição crescente nos domínios da biodiversidade e da biotecnologia. O estudo destes ambientes extremos é relevante para futuras aplicações num vasto leque de domínios, incluindo o biomédico e o farmaceutico, mas também se estende à descoberta de novos materiais úteis e ao fornecimento de conhecimentos úteis para futuros esforços de exploração espacial. Estão actualmente a ser investigadas outras amostras provenientes destes locais e espera-se que nos próximos meses sejam publicadas novas publicações descrevendo outras espécies novas.
Example of different types of colonies obtained during this study
Example of different types of colonies obtained during this study
 The Salterns of Rio Maior (Portugal)
The Salterns of Rio Maior (Portugal)









